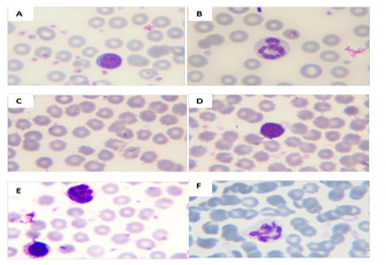

1Laboratoire de Génie Microbiologique et Application, Equipe de Biologie physiologie Cellulaire & moléculaire, Université Frères Mentouri Constantine 25000, Algeria, 2Ecole Nationale Supérieure de Biotechnologie, nouveau pôle Ali Mendjli, Constantine, Algeria.
Email: aggounccherifa@gmail.com
Received: 08 Nov 2014 Revised and Accepted: 05 Dec 2014
ABSTRACT
Objective: The present study evaluates the effects of methionine supplementation on the thymus histology and the peripheral blood in albino Wistar rats.
Methods: The animals were divided into two groups. The experimental group (Met)(500mg/Kg /day, orally) and the control (C). Blood was collected for C reactive protein (CRP), total protein, Malondialdehyde (MDA) and blood smear tests, then thymuses were harvested for Histology and immune histochemistry.
Results: Methionine intake caused an increase in CRP (P<0, 01), total protein (P<0,001) and MDA levels (P<0, 01) in addition to several hematological changes expressed by crenation of red blood cell membranes and irregular leucocyte nuclei. Histological investigation of experimental thymus gave dramatic involution of lobules and presented of apoptotic zones especially in the medulla. Immuno histochemical expression of VEGF- A were positive in septa and blood vessels at the corticomedullary junction.
Conclusion: Methionine supplementation produces hematological changes, a thymic involution, and seemed to promote the angiogenesis process in the thymus of adult rats.
Keywords: Methionine, Thymus, Blood cells, VEGF-A, Histopathology, Involution, Angiogenesis.
INTRODUCTION
Methionine is an essential sulfured amino acid given only through diet. Under physiological conditions, methionine plays a pivotal role in several processes such as DNA methylation, protein synthesis, antioxidant status and hepatic fat reduction [1]. Thus, its consumption has been widely discussed in both epidemiology [2, 3] and experimentation [4-6].
In mammals, many reports defined the pathophysiological effects of high methionine intake on the liver [7], the brain [8], the heart [9], and the kidney [10]. Conversely, those on the immune system and in particular the thymus are poorly investigated [11], except some studies in poultry that reported the protective and beneficial effect of this supplementation on the thymus [12, 13].
Histologically, the thymus is composed of two identical lobes; each one can be divided into a central medulla and a peripheral cortex which are surrounded by a capsule. The adult thymus is supplied by branches of the inferior thyroid and internal thoracic arteries that enter the thymus at the cortico-medullary junction. These arterioles form ascend capillaries in the cortex and curve back down to the medulla where they are organized into post capillary venules [14].
Furthermore, previous papers of nutrition toxicity considered methionine as the most toxic amino acid in animals, and indicated that its conversion to homocysteine (Hcy) is the principal notable cause of this effect [15, 16]. It is hypothesized that Hcy has vasculotoxic properties enhancing the production and the accumulation of Reactive Oxygen Species (ROS), which causes endothelial cell injuries and dysfunction [17, 18].
In addition, it has been reported that hyper homocysteinemia increases VEGF-A expression. This peptide (Vascular Endothelial Growth Factor-A), promotes angiogenesis in normal and pathological conditions in many pathologies such as atherosclerosis, diabetes mellitus and cancer [19, 20]. But no interaction was demonstrated on the thymus.
However, some studies described a positive correlation between morphogenesis of thymic vasculature and VEGF-A expression in fetal and postnatal life; they concluded that a development of the normal vessels’ architecture required a high production of VEGF-A by the Thymic Epithelial Cells (TECs) [21, 22].
Ansari et al. [23], Rasouli et al. [24] observed that methionine intake induce hematological changes both histologically and as a count. The aim of this work is first to investigate effects of methionine on blood cells and the thymus structure, then to check if the methionine could exert reparative angiogenesis on the thymus.
MATERIALS AND METHODS
Animals and treatments
Male albino Wistar rats used were 8 weeks old; they were procured from Pasture Institute, Algiers, Algeria, and were maintained at animal house of animal biology department, freres mentouri univesity, Constantine.
The animals were divided into two groups (n=8 each): the experimental group (Met) and the control (C), and they were housed three rats per cage, under controlled conditions (25°C) and given food and water ad libitum. The composition of diet in proteins and methionine was determined as 30mg proteins and 4,5mg methionine per 200g of diet. After one week of acclimation, the experimental group was fed the same diet as the control except for the addition of L-methionine (500mg/Kg /day, orally) from Sigma (St. Louis, MO, USA). The animals were treated daily for 8 weeks.
Preparation of samples and tissue extracts
At the end of treatment, after 12 hours of fasting blood samples were collected from the cavernous sinus using sterile microcapillary tube; first for the mounting of blood smear slides, and later for the estimation of CRP and total proteins. After that, animals were anaesthetized with chloroform, and perfused through the heart with (PBS) followed by 4 mM paraformaldehyde in (PBS), then thymuses and livers were removed for histological study, the immune histochemical and Determination of liver lipid peroxidation investigations.
CRP assay
CRP serum levels were measured by an Immuno turbidimetric method using commercial Randox kit (UK) with standards provided by the same firm, and expressed in mg/L.
Protein assay
The protein content of plasma was estimated spectro photometrically, according to the method of Bradford [25], using bovine serum albumin as standard.
Determination of liver lipid peroxidation
MDA is one of the terminal products of lipid peroxidation induced by free radicals. Under hot (T=100°c) and acidity conditions. MDA and TBA (2‑thiobarbutric acid) formed a chromophore which is removed by butanol and absorbing at 532 nm. Levels of MDA were measured in cytosolic fractions from 1g of frozen liver according to the method of Lqbal et al.[26]. The supernatants resulting were analyzed by the method of Lefevre et al. [27]. MDA production was expressed in µM /mg proteins/g of tissue.
Peripheral blood smear test
Hematology changes were defined in whole blood, and visualized by May GrÜnwald –Giemsa (MGG) staining.
Histology and immune histochemistry
Thymic tissues were fixed in 10% buffered formaldehyde for 24H, and paraffin embedded according to the standard technique. For histological study, tissues were sectioned and stained with Hematoxyl in and eosin (H&E).
For immunostaining, it was performed by using the method of streptavidin‑biotin complex. The sections were deparraffinized and the endogenous peroxidase was blocked with H2O2 (3%) for 30 min. After two washes in PBS, BSA (1%) (Sigma, St. Louis, MO, USA) was applied to sections for 30 min to block the nonspecific binding. Tissues were incubated with primary antibody: Rabbit polyclonal VEGF antibody (Santa‑Cruz Biotechnology, Santa Cruz, California) at a dilution of 1:100 overnight at room temperature.
After that, sections were washed in PBS, and then treated with anti‑rabbit biotinylated antibody diluted at 1:100 (Santa‑Cruz Biotechnology, Santa Cruz, California) for 24h at room temperature; washed with PBS and coated with peroxidase 1:100 for 2h. Di amino benzidine (DAB) was used to visualize the antibody, and the tissues were counter stained with Mayer’s Hematoxylin, then dehydrated and covered with strips. Slides in both the histological and immune histochemistry studies were examined under light microscope (EXACTA + OPTECH GMBH-MÜnchen, Germany), equipped with a digital camera (Canon DS126181, Japan).
Statistical analyses
Data was expressed as mean ± standard error of the mean (M ±SEM). Comparison and association between the groups was performed by Student’s t-test using (SPSS 9. O) program. Differences were considered significant at P<0,05.
RESULTS
Inflammatory markers
The CRP level from rats of the group treated with methionine was significantly higher compared to the control (P<0, 01), (Table 1).
Plasma protein levels were significantly increased in the Met group compared with the control (P<0,001), (Table 1).
Hepatic MDA levels
We noted a significant increase in the lipid peroxide level in group Met compared to the control (P<0, 01), (Table 1).
Table 1: CRP (mg/l), total proteins (mg/ml) and MDA levels (µM /mg proteins/g of tissue) of rats treated with methionine
| Groups | CRP | Total protein | MDA |
| Control (C) | 0.27±0.039 | 5.64±0.38 | 8.80±6.40 |
| Met supplementation (M) | 0.39±0.17** | 5.93±0.33*** | 15.27±5.85** |
Values are mean±S. E. M. (n=8). (**): Significantly at P<0.01, (***): Significantly at P<0.001
Effect of methionine on blood cells
In routine MGG stain, the control smear was diagnosed with well‑ known morphology of nucleus and membrane of various blood cells including erythrocytes, lymphocytes and polymorphonuclear cells (PMNs) (Fig.1A, B).
Fig. 1: Heamatological changes in control and methionine supplementation groups. (MGG stain x400).(A,B) control rat showing erythrocytes with regular membrane, lymphocytes with uniformly stained nucleus surrounded by a thin circle of cytoplasm, a presence of platelets, and normal morphology of PMN cells. (C, D, E, F) Met rat showing, erythrocytes crenation, lymphocytes and monocyte with irregular and compact nucleus, PMN with hyper segmented nucleus
However, in the Met group, red cells appeared in the form of spherocytes: hyper chromateus cells without a central clear zone, and the acanthocytes: crenelated cells with irregular extension on the surface (Fig.1C).
Lymphocytes and monocytes presented an irregular nucleus with a scattering chromatin, as shown in (Fig.1D,E). PMNs were defined by hyper segmentation of nucleus compared with those in control smear (Fig. 1F).
Effect of methionine on thymus histopathology
Histology analysis revealed that thymus in control group was arranged into two distinct compartments: The cell‑dense cortex containing thymocytes and the less dense medulla dominated by mature T cells and Hassal’s corpuscules (Fig. 2A, B). Some apoptotic zones were also identified in cortex (Fig. 2C).
However, Met lobules (Fig. 2D, E) appeared with a dramatic involution, a marked presence of adipose tissue, and more apoptotic areas especially in the medulla where lymphocytes are decreased in number.
Effect of methionine on VEGF expression
The immuno‑staining for VEGF was different in the two groups of rats. In fact, control thymuses presented a positive expression especially in the subcapsular zone (Fig.3A, B), contrary to Met thymuses that expressed VEGF positively in the medulla, septa and blood vessels of the cortico medullary junction (Fig.3C, D, E).

Fig. 2: Histopathological changes in the thymus of control group and methionine supplementation. (H&E). Thymus of control rat (A, 40x), showing several lobules (L) delimited by a connective tissue septum (S), and subdivided into cortex (C) and medulla (M). Theheavy staining of the cortex is due to the closely packed small lymphocytes. The medulla also contains lymphocytes, but these cells are spaced by larger cells that are lightly stained. Venules (V), capillaries (Ca) and Hassall’s, corpuscle are also identified(B, 100x). The apoptotic zone (AZ)is shown at a higher magnification (C, 400x). Thymus of Met rat showing involution in lobule (D, 40x) with remarkably decreased number of lymphocytes expressed by apoptotic zones (AZ) (E, 400x)

Fig. 3: Effect of methionine on VEGF expression (IHC, anti-VEGF-A, DAB). In control thymus (A, 100x),(B, 400x) positive VEGF expression in subcapsular of lobules. In Met thymus, positive epithelial cells for VEGF in septa (C, 40x), endothelial cells positive for VEGF in a septum (D, 400x) and positive blood vessels (BV) for VEGF at the corticomudullary junction (E, 400x)
DISCUSSION
In literature, methionine supplementation is considered as an experimental method to produce hyper homocysteine miamodels [28, 29, 30].
As markers of inflammation, CRP and total protein were founded to be strongly increased in Met group (Tableau.1). These results were in agreement with others [31,32]. Moreover, there is a significant correlation between Hcy concentration and inflammatory parameters [33].
In terms of oxidative stress, our findings showed that hepatic MDA was significantly higher in Met group compared to the control. This is in accordance with previous studies [7,34,35], where it was reported that methionine supplementation altered antioxidant status through increased plasma Hcy levels. Hcy acts in several processes including: generation and accumulation of reactive oxygen species (ROS), inhibition of glutathione peroxidase, auto oxidation and oxidation of LDL [17, 36].
In our findings, red cells, LT and PMN appeared with significant disorders in size and nuclear morphology compared to the control (Fig.1). For red cells, Benevenga et al.[37]and Nigam et al.[38], have reported that excessive intake of methionine causes typical hematological changes (shrinkage of erythrocytes giving notched appearance),which lead to hemolytic anemia. Recently many papers described the expression of N-methyl-D-aspartate (NMDA) receptors in immune competent cells[39, 40]and also in red blood cells [41]. Their function was found to be regulated by plasma levels of HCY and Homocysteic acid (oxidative derivative). The first one induced toxicity and DNA damage; whereas the second one produced cell apoptosis. The decrease of cell size was observed in both [42, 43]. Similar data were shown in (Fig. 1 C, D, E, F). It is suggested that hyper activation of NMDA receptors caused a rapid entry of Ca2+ into the cells, associated with an accumulation of ROS and an increase in thrombosis incidence which leads to disorders in signaling pathways [44].
Histological results showed that methionine supplementation markedly induced thymic lesions expressed by apoptotic zones and atrophic lobules (Fig. 2D, E). Quaglino et al.[45] reported that high ROS levels associated with lower concentration of glutathione caused cell apoptosis and may contribute to the thymic involution process. Since the discovery of NMDA receptors in immune competent cells, many investigators described the apoptotic effects of Hcy on lymphocytes and hypothesed the involvement of ROS accumulation [42].
In addition Hcy can induce DNA damage of lymphocytes via disruption of DNA methylation and alterations of cell cycle markers [46]. For the dilatation of septa, Hcy is responsible for the endothelium injuries mediated by methionine, which is largely demonstrated in research conducted on animals and humans [4, 47].
So, the histological effects of methionine diet can be considered as an evidence event of hyperhomocysteinemia, which was first supported by inflammatory markers, MDA levels and hematological changes.
To investigate whether methionine supplementation causes reparative angiogenesis in the thymus, we revealed the localization of VEGF signal. It has been demonstrated that both the formation and the organization of thymus vasculature are VEGF dependent [21]. Later, Andrew et al. [48, 49] in their two papers, confirmed that development and reconstitution of thymic endothelium are regulated by local production of VEGF by TECs, and possibly also by specific immature thymocytes. These findings were just shown in neonate murine thymus but not in the adult.
Other authors defined the association between morphogenesis of the normal thymus and aging; after birth VEGF levels flow in a decreasing order [50, 51]. These data support our results in the control thymuses (Fig.3A, B) where VEGF expression was localized essentially in the subcapsular epithelial cells.
However, HyunJoo et al. [52] reported that VEGF signals were detected in the TECs cytokeratine positive during thymic regeneration, and concluded that thymic regeneration accompanies reparative angiogenesis after acute involution induced by cyclophosphamide CY in adult rat. Cimpeana et al.[51]showed the same findings in the human thymus from acute involution but also with positive VEGF in dilated blood vessels.
This is in accordance with our observations from Met thymuses; i. e. the positive expression in septa and blood vessels at the corticomedullary junction (Fig. 3C, D, E). Series of works revealed a significant correlation between Hcy and VEGF expression, and confirmed that changes in plasma Hcy directly affected plasma level and the expression of VEGF [20, 53].
CONCLUSION
In the present study it has been found that methionine supplementation caused on the one hand, inflammatory markers and MDA imbalance, hematological changes and thymic involution; and on the other hand, led to the start of reparative angiogenesis of the thymus as demonstrated by an increase in VEGF expression. We suggest that VEGF was produced locally when thymic regeneration had occurred after the involution and/or it can be moved by blood circulation after endothelium damage indirectly induced by methionine. In parallel, a previous study in our laboratory showed strong injuries in the thymus tissue in rats receiving immunosuppressive treatment (paper under publication); thus, we believe that patients, who are under the immune suppressive therapy, should reduce animal protein intake with high methionine content.
CONFLICT OF INTERESTS
Declared None
REFERENCES